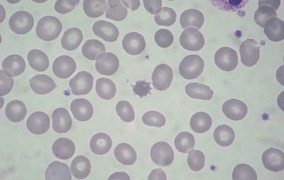

Busca - 39433 notícias encontradas
-
IPT abre inscrições para o programa Novos Talentos
23 de março de 2017São, ao todo, 34 vagas para mestrado, doutorado e pós-doutorado; prazo de inscrição encerra em 20 de abril -
Workshop on Science Dissemination, Animal Biology and Neuroscience
23 de março de 2017Museus e universidades britânicas participam de evento com pesquisadores do Butantan -
Olhares para o Método Científico
23 de março de 2017Seminário no IFUSP debaterá como a definição clássica de método científico reflete o processo de criação nas ciências -
FAPESP tem listas tríplices para diretores Científico e Administrativo
23 de março de 2017Conselho Superior compõe listas tríplices que serão entregues ao governador de São Paulo para escolha dos executivos -
Efeito quântico possibilita codificar mais informações em microchip
22 de março de 2017Fenômeno poderá ser utilizado em tecnologias de processadores e em diferentes tipos de sensores -
Pesquisas sobre moléculas da biodiversidade e sobre poluentes são foco de novos INCTs
22 de março de 2017INCT-Bionat e INCT-Datrem, com apoio da FAPESP e do CNPq, reunirão dezenas de pesquisadores brasileiros -
Oportunidade de Pós-Doutorado em Ortopedia
22 de março de 2017Candidato selecionado terá bolsa custeada pelo Hospital Israelita Albert Einstein; prazo de inscrição encerra em 31 de março -
Professores da rede pública são capacitados em Computação e Robótica
22 de março de 2017Aulas práticas contam com kits robóticos financiados pelo CeMEAI -
Instituto de Física da USP seleciona docente por prazo determinado
22 de março de 2017Professor atuará junto ao Departamento de Física Matemática; prazo de inscrição encerra em 29 de março -
Intersections III - International Cooperative Cancer Symposium
22 de março de 2017Pesquisas recentes e o futuro do tratamento do câncer serão debatidos em evento no Sírio-Libanês, em São Paulo -
IV Encontro Internacional de Teoria e Análise Musical
22 de março de 2017Com o tema “Análise musical e teoria aplicada: confluências e continuidades”, evento na ECA-USP recebe submissão de trabalhos até 5 de abril -
Grupo da USP investiga como a fototerapia combate a dor neuropática
21 de março de 2017Em experimentos com ratos, pesquisadores do ICB investigam mecanismos terapêuticos da fototerapia de baixa intensidade -
Escola de Ciência Avançada em Proteômica tem 90 vagas para estudantes
21 de março de 2017Evento será sediado no CNPEM, em Campinas, de 28 de agosto a 6 de setembro. Inscrições para brasileiros e estrangeiros encerram em 9 de abril -
Pós-Doutorado em Fisiologia Cardiovascular com Bolsa da FAPESP
21 de março de 2017Bolsa está vinculada a Projeto Temático que estuda mecanismos de controle envolvidos em hipertensão e obesidade; prazo de inscrição encerra em 31 de março -
Oportunidade de doutoramento em Física na Espanha
21 de março de 2017Brasileiros podem se candidatar a bolsa para pesquisa em Física da Matéria Condensada na Universidade Autónoma de Madrid -
I Seminário Internacional Arquivos, Mulheres e Memórias
21 de março de 2017Evento em São Paulo tem como objetivo pensar os arquivos como espaços para a valorização da memória feminina e como fontes para a escrita da história -
Darwin Day Unesp
21 de março de 2017Encontro no Instituto de Biociências de Botucatu abordará temas como “Evolução adaptativa”, “Neodarwinismo” e “Revolução genômica” -
SPAnet vai conectar toda a pesquisa astronômica realizada em São Paulo
20 de março de 2017Comitê Gestor da São Paulo Astronomy Network, constituído em workshop realizado na FAPESP, fará cadastro de empresas com potencial de atuação no campo da instrumentação astronômica -
ESPCA em Metodologia em Ciências Humanas abre inscrições
20 de março de 2017Escola São Paulo de Ciência Avançada capacitará para o uso de técnicas que têm revolucionado pesquisas na área, como a análise computacional de grandes volumes de dados -
Treinamento Técnico em Bioquímica com Bolsa da FAPESP
20 de março de 2017Bolsista atuará junto ao Centro de Biologia Química de Proteínas Quinases, vinculado ao SGC. Inscrições até 30 de março -
Pós-Doutorado em Produção de Hidrogênio com Bolsa da FAPESP
20 de março de 2017Bolsa está vinculada ao Centro de Pesquisa para Inovação em Gás Natural com sede na Poli-USP. Prazo de inscrição encerra em 31 de março -
Universidade Humboldt abre programa para jornalistas brasileiros
20 de março de 2017Iniciativa terá duração de dois meses, com despesas pagas. Podem se candidatar profissionais especializados em divulgação científica -
3rd BIPMed Workshop and 1st Meeting of the Steering Committee HVP-Brazilian Node
20 de março de 2017Evento será realizado na Faculdade de Ciências Médicas da Unicamp durante o 4th BRAINN Congress -
Euclid and the Origin of the Accelerating Universe
20 de março de 2017Yannick Mellier, do Institut d'Astrophysique de Paris, falará no IAG sobre missão que investigará natureza da matéria e da energia escura -
Camarões camaleônicos
17 de março de 2017Cientistas descobrem espécie de crustáceo que muda de cor para se camuflar entre algas e tentar escapar de predadores -
Escola São Paulo de Ciência Avançada em Mudanças Climáticas aceita inscrições
17 de março de 2017Estudantes de pós-graduação e pesquisadores em início de carreira têm até o dia 31 de março para se candidatar a participar do evento -
Pós-Doutorado em Mudanças Climáticas em Pastagem com Bolsa da FAPESP
17 de março de 2017Bolsista integrará equipe de Projeto Temático desenvolvido na Unesp de Jaboticabal; prazo de inscrição encerra em 30 de março -
Inscrição para o Prêmio Gutierrez de melhor tese em matemática encerra em 31 de março
17 de março de 2017O valor do prêmio é equivalente ao de uma mensalidade da bolsa de doutorado da Coordenação de Aperfeiçoamento de Pessoal de Nível Superior -
Escola São Paulo de Ciência Avançada em Proteômica Baseada em Espectrometria de Massas
17 de março de 2017Inscrições abertas até 9 de abril para estudantes do Brasil e do exterior interessados em participar da Escola no CNPEM apoiada pela FAPESP -
Diálogo sobre Apoio à Pesquisa para Inovação na Pequena Empresa
17 de março de 2017FAPESP realiza evento para esclarecer dúvidas sobre apresentação de propostas ao programa PIPE
Mais lidas do mês
-
Corpo aproveita pouco os minerais das castanhas, diz estudo que simulou a digestão humana
11 de junho de 2026
-
São Paulo terá a primeira usina do país para capturar e armazenar carbono do etanol de cana
11 de junho de 2026
-
Pesquisadoras descobrem nova espécie de microrganismo adaptado a frio e calor extremos na Antártida
01 de junho de 2026
-
Relógio inteligente detecta ansiedade e estresse em tempo real
08 de junho de 2026
-
Combinação de metais abundantes pode baratear produção de hidrogênio verde
02 de junho de 2026
-
Projeto vai oferecer teste genético gratuito para casais que planejam ter filhos
09 de junho de 2026
-
Parceria científica entre Brasil e Argentina resiste a crises e fragmentação geopolítica
02 de junho de 2026
-
Pesquisa contesta suposto efeito anti-inflamatório da creatina
10 de junho de 2026
-
Brasil precisa superar gargalos ambientais e tecnológicos para viabilizar mineração de terras-raras
03 de junho de 2026
-
Novo modelo físico explica rotação retrógrada de Vênus como resultado natural da evolução planetária
01 de junho de 2026